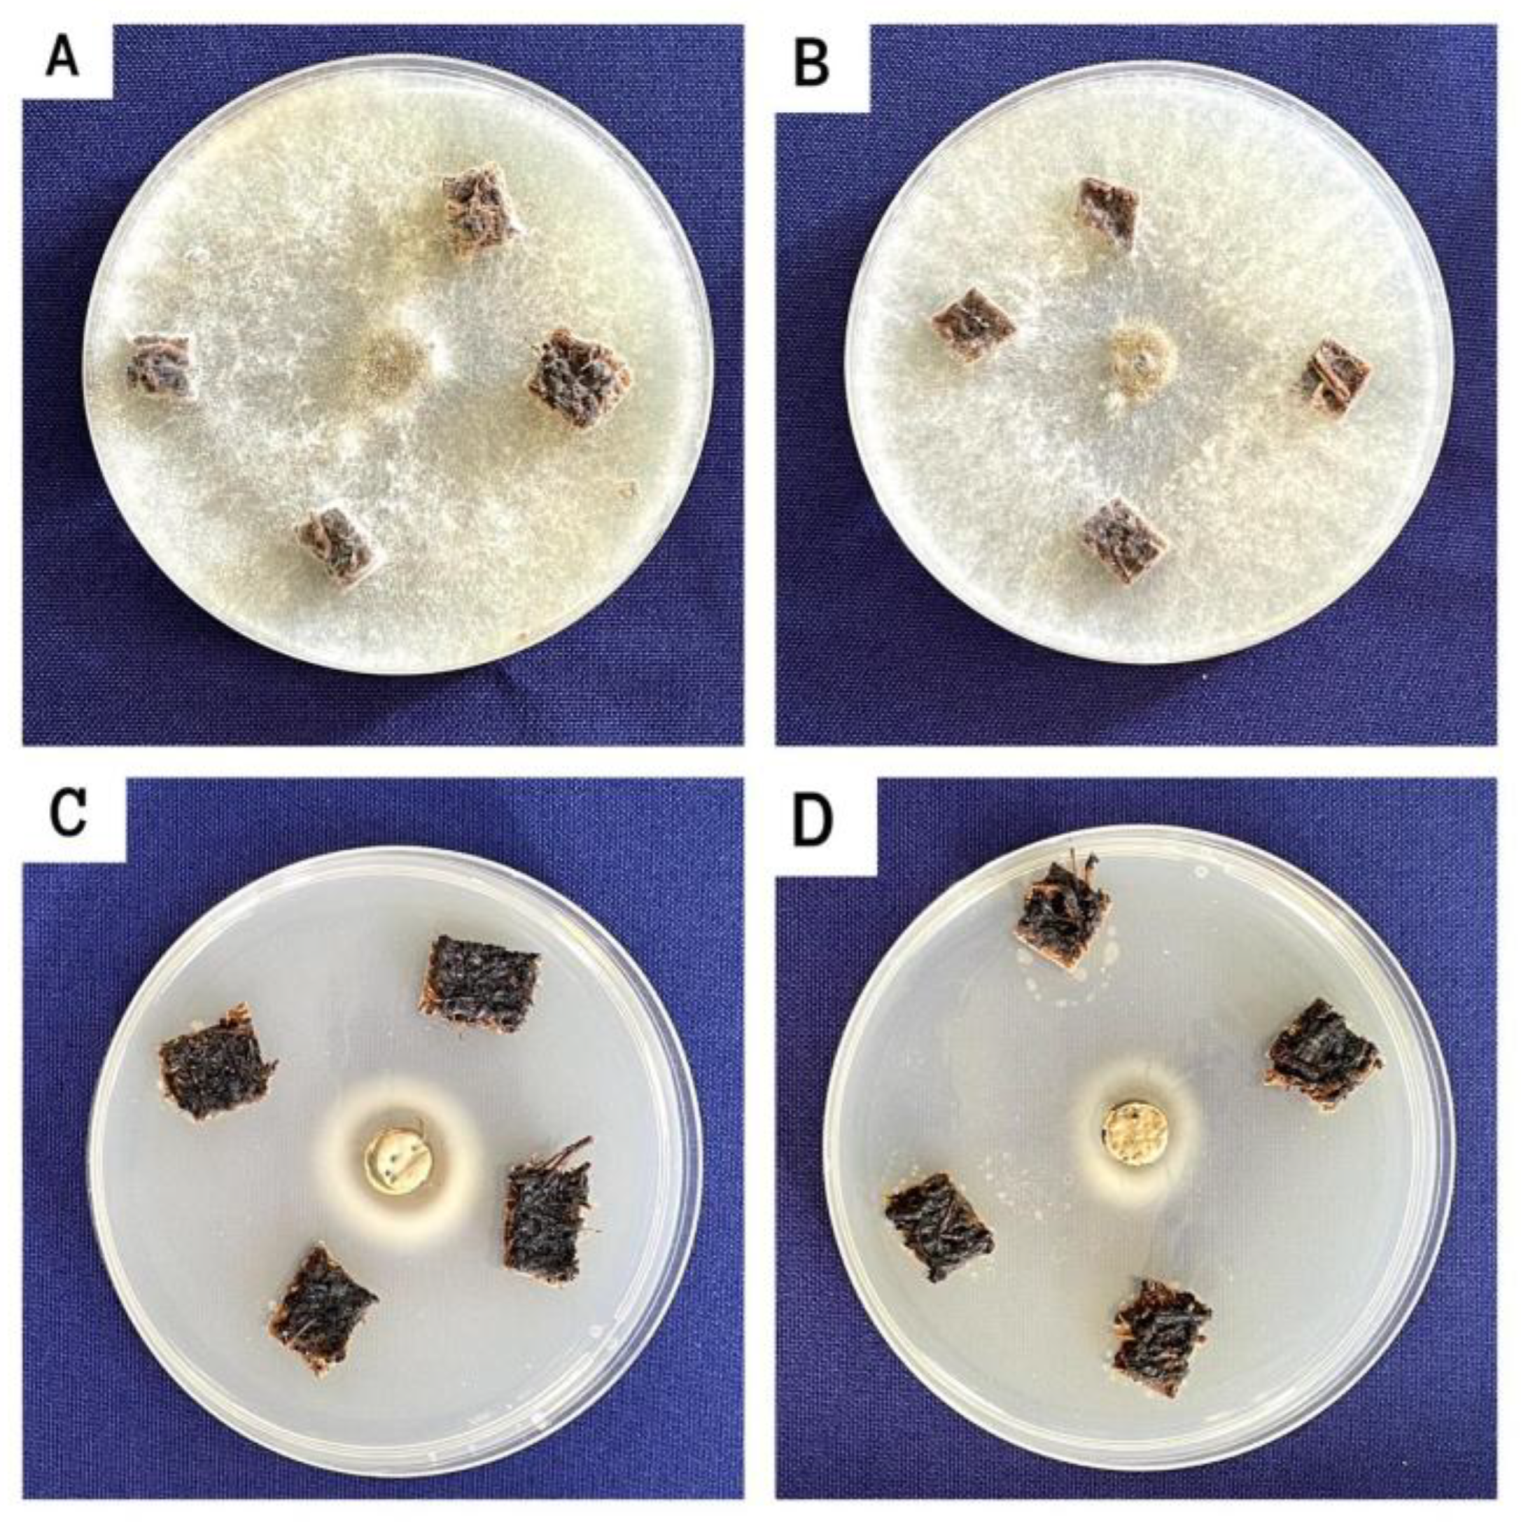
Preprints 156386 g004

Submitted:
18 April 2025
Posted:
18 April 2025
You are already at the latest version
Abstract
Keywords:
1. Introduction
2. Materials and Methods
2.1. Materials
2.2. Obtaining Aquafaba (Aq)
2.3. Biomaterial preparation
2.4. Experimental Design and Formulation
2.5. Physicochemical Characterization of the Material
2.5.1. Chemical Composition
2.5.2. Water Absorption Capacity
2.5.3. Mechanical Properties and Morphology
2.6. Biodegradability
2.7. Microbiological Analysis
2.8. Statistic Analysis
3. Results
3.1. Characterization of Mechanical and Physicochemical Properties of the Biomaterial
3.2. Biomaterial Morphology and Microstructure
3.3. Biodegradability
3.4. Microbiological Analysis
4. Discussion
4.1. Characterization of Mechanical and Physicochemical Properties of the Biocomposite Material
4.2. Biomaterial Morphology and Microstructure
4.3. Biodegradability
4.4. Microbiological Analysis
5. Conclusions
Author Contributions
Funding
Data Availability Statement
Acknowledgments
Conflicts of Interest
References
- Vazquez, A.; Valdemar, R.M.E.; Villavicencio, M.B.; Pérez, M.V. Reciclaje de plásticos; Universidad Autónoma de México, 2016;
- Bueno, D.; Brienzo, M. Production of Bioplastics with Chemical and Enzymatic Modificated Xylan (Lignin- and Arabinose-Free) from Sugarcane Bagasse. Biotechnol Sustain Mater 2025, 2, 2. [CrossRef]
- Soni, P. Comparison between Corn and Potato Starch-Based Bioplastic : Thermal Variation 2023.
- Molla, A.; Haque, J.; Moyeen, A.A.; Mahmud, R.M. Plant Fiber-Reinforced Green Composite: A ... Materials Open Research 2024, 3.
- Almeida, V.H.M.; Jesus, R.M.; Santana, G.M.; Pereira, T.B. Polylactic Acid Polymer Matrix (Pla) Biocomposites with Plant Fibers for Manufacturing 3D Printing Filaments: A Review. Journal of Composites Science 2024, 8, 67. [CrossRef]
- Zidi, S.; Miraoui, I. Mechanical and Morphological Analysis of Cellulose Extracted from Sisal Fibers and Their Effect on Bio-Based Composites Mechanical Properties. Funct. Compos. Struct. 2024, 6, 015008. [CrossRef]
- Patil, S.P.; Baikar, P.; Tayade, R.R.; Patil, S.P.; Baikar, P.; Tayade, R.R. Surface Modification of Nano Cellulose: The Path to Advanced Uses of Smart and Sustainable Bio-Material. GSC Advanced Research and Reviews 2023, 17, 127–137. [CrossRef]
- Hasanin, M.S. Cellulose-Based Biomaterials: Chemistry and Biomedical Applications. Starch - Stärke 2022, 74, 2200060. [CrossRef]
- Salgado, P.R.; Schmidt, V.C.; Molina Ortiz, S.E.; Mauri, A.N.; Laurindo, J.B. Biodegradable Foams Based on Cassava Starch, Sunflower Proteins and Cellulose Fibers Obtained by a Baking Process. Journal of Food Engineering 2008, 85, 435–443. [CrossRef]
- Engel, J.B.; Ambrosi, A.; Tessaro, I.C. Development of Biodegradable Starch-Based Foams Incorporated with Grape Stalks for Food Packaging. Carbohydrate Polymers 2019, 225, 115234. [CrossRef]
- Motloung, M.P.; Ojijo, V.; Bandyopadhyay, J.; Ray, S.S. Cellulose Nanostructure-Based Biodegradable Nanocomposite Foams: A Brief Overview on the Recent Advancements and Perspectives. Polymers 2019, 11. [CrossRef]
- Obradovic, J.; Voutilainen, M.; Virtanen, P.; Lassila, L.; Fardim, P. Cellulose Fibre-Reinforced Biofoam for Structural Applications. Materials 2017, 10, 619. [CrossRef]
- Mejía, Nora; Campoverde, Diana Estudio Comparativo de Propiedades Funcionales y Fisicoquímicas de Aquafaba de Distintas Leguminosas. AlfaPublicaciones 2022, 4, 35-50.
- Erem, E.; Icyer, N.C.; Tatlisu, N.B.; Kilicli, M.; Kaderoglu, G.H.; Toker, Ö.S. A New Trend among Plant-Based Food Ingredients in Food Processing Technology: Aquafaba. Crit Rev Food Sci Nutr 2023, 63, 4467–4484. [CrossRef]
- Thomas-Meda, A.; Vela-Gutiérrez, G.; Tavano, O.L.; Tacias-Pascacio, V.G. Effect of Processing Conditions on the Functional Properties of Aquafaba from Natural Chickpeas: Valorization of a Food Waste. Biotecnia 2023, 25, 23–29.
- Ruvalcaba, U. Mejoramiento de las características bromatológicas (proteína) del aquafaba en SESAJAL, Universidad Jesuita de Guadalajara, 2022.
- Andrieux, S.; Medina, L.; Herbst, M.; Berglund, L.A.; Stubenrauch, C. Monodisperse Highly Ordered Chitosan/Cellulose Nanocomposite Foams. Composites Part A: Applied Science and Manufacturing 2019, 125, 105516. [CrossRef]
- Hassan, M.M.; Tucker, N.; Le Guen, M.J. Thermal, Mechanical and Viscoelastic Properties of Citric Acid-Crosslinked Starch/Cellulose Composite Foams. Carbohydrate Polymers 2020, 230, 115675, doi:Huff.
- Kargarzadeh, H.; Huang, J.; Lin, N.; Ahmad, I.; Mariano, M.; Dufresne, A.; Thomas, S.; Gałęski, A. Recent Developments in Nanocellulose-Based Biodegradable Polymers, Thermoplastic Polymers, and Porous Nanocomposites. Progress in Polymer Science 2018, 87, 197–227. [CrossRef]
- Spigno, G.; Pizzorno, T.; De Faveri, D.M. Cellulose and Hemicelluloses Recovery from Grape Stalks. Bioresource Technology 2008, 99, 4329–4337. [CrossRef]
- Cruz-Tirado, J.P.; Barros Ferreira, R.S.; Lizárraga, E.; Tapia-Blácido, D.R.; Silva, N.C.C.; Angelats-Silva, L.; Siche, R. Bioactive Andean Sweet Potato Starch-Based Foam Incorporated with Oregano or Thyme Essential Oil. Food Packaging and Shelf Life 2020, 23, 100457. [CrossRef]
- Debiagi, F.; Kobayashi, R.K.T.; Nakazato, G.; Panagio, L.A.; Mali, S. Biodegradable Active Packaging Based on Cassava Bagasse, Polyvinyl Alcohol and Essential Oils. Industrial Crops and Products 2014, 52, 664–670. [CrossRef]
- Ago, M.; Ferrer, A.; Rojas, O.J. Starch-Based Biofoams Reinforced with Lignocellulose Nanofibrils from Residual Palm Empty Fruit Bunches: Water Sorption and Mechanical Strength. ACS Sustainable Chem. Eng. 2016, 4, 5546–5552. [CrossRef]
- Blomfeldt, T.O.J.; Olsson, R.T.; Menon, M.; Plackett, D.; Johansson, E.; Hedenqvist, M.S. Novel Foams Based on Freeze-Dried Renewable Vital Wheat Gluten. Macromol. Mater. Eng. 2010, 295, 796–801. [CrossRef]
- Meurer, M.C.; De Souza, D.; Ferreira Marczak, L.D. Effects of Ultrasound on Technological Properties of Chickpea Cooking Water (Aquafaba). Journal of Food Engineering 2020, 265, 109688. [CrossRef]
- Cabanillas, A.; Nuñez, J.; Cruz-Tirado, J.; Vejarano, R.; Tapia-Blácido, D.R.; Arteaga, H.; Siche, R. Pineapple Shell Fiber as Reinforcement in Cassava Starch Foam Trays. Polymers and Polymer Composites 2019, 27, 496–506. [CrossRef]
- Matsuda, D.K.M.; Verceheze, A.E.S.; Carvalho, G.M.; Yamashita, F.; Mali, S. Baked Foams of Cassava Starch and Organically Modified Nanoclays. Industrial Crops and Products 2013, 44, 705–711. [CrossRef]
- Pelissari, F.M.; Grossmann, M.V.E.; Yamashita, F.; Pineda, E.A.G. Antimicrobial, Mechanical, and Barrier Properties of Cassava Starch−Chitosan Films Incorporated with Oregano Essential Oil. J. Agric. Food Chem. 2009, 57, 7499–7504. [CrossRef]
- The Jamovi Project 2023.
- Iseppi, R.; Truzzi, E.; Sabia, C.; Messi, P. Efficacy and Synergistic Potential of Cinnamon (Cinnamomum Zeylanicum) and Clove (Syzygium Aromaticum L. Merr. & Perry) Essential Oils to Control Food-Borne Pathogens in Fresh-Cut Fruits. Antibiotics 2024, 13, 319. [CrossRef]
- He, Y.; Meda, V.; Reaney, M.J.T.; Mustafa, R. Aquafaba, a New Plant-Based Rheological Additive for Food Applications. Trends in Food Science & Technology 2021, 111, 27–42. [CrossRef]
- Crawford, K.; Tyl, C.; Kerr, W. Evaluation of Processing Conditions and Hydrocolloid Addition on Functional Properties of Aquafaba. Foods 2023, 12, 775. [CrossRef]
- Sanhawong, W.; Banhalee, P.; Boonsang, S.; Kaewpirom, S. Effect of Concentrated Natural Rubber Latex on the Properties and Degradation Behavior of Cotton-Fiber-Reinforced Cassava Starch Biofoam. Industrial Crops and Products 2017, 108, 756–766. [CrossRef]
- Nabar, Y.; Raquez, J.M.; Dubois, P.; Narayan, R. Production of Starch Foams by Twin-Screw Extrusion: Effect of Maleated Poly(Butylene Adipate-Co-Terephthalate) as a Compatibilizer. Biomacromolecules 2005, 6, 807–817. [CrossRef]
- Hosseini, S.M.H.; Razavi, S.; Mousavi, M. Antimicrobial, Physical and Mechanical Properties of Chitosan-Based Films Incorporated with Thyme, Clove and Cinnamon Essential Oils. Journal of Food Processing and Preservation 2009, 33, 727–743. [CrossRef]
- Chiellini, E.; Cinelli, P.; Ilieva, V.I.; Imam, S.H.; Lawton, J.W. Environmentally Compatible Foamed Articles Based on Potato Starch, Corn Fiber, and Poly(Vinyl Alcohol). Journal of Cellular Plastics 2009, 45, 17–32. [CrossRef]
- Benavides, S.; Villalobos-Carvajal, R.; Reyes, J.E. Physical, Mechanical and Antibacterial Properties of Alginate Film: Effect of the Crosslinking Degree and Oregano Essential Oil Concentration. Journal of Food Engineering 2012, 110, 232–239. [CrossRef]
- Caiza, J.C.; Vargas, D.; Olmedo, C.; Arboleda, M.; Boada, L.; Acurio, O.; Arroyo, C.; Debut, A.; Segovia-Salcedo, M. Morfometría y Morfología de Estomas y de Polen Como Indicadores Indirectos de Poliploidía En Especies Del Género Polylepis (Rosaceae) En Ecuador. Ecología austral 2018, 28, 175–187.
- Tapia-Blácido, D.; Mauri, A.N.; Menegalli, F.C.; Sobral, P.J.A.; Añón, M.C. Contribution of the Starch, Protein, and Lipid Fractions to the Physical, Thermal, and Structural Properties of Amaranth ( Amaranthus Caudatus ) Flour Films. Journal of Food Science 2007, 72. [CrossRef]
- Versino, F.; López, O.V.; García, M.A. Sunflower Oil Industry By-Product as Natural Filler of Biocomposite Foams for Packaging Applications. J Polym Environ 2021, 29, 1869–1879. [CrossRef]
- Torres, L.C. Efecto sinérgico del aceite esencial de Origanum vulgare a la Gentamicina en cultivos de Escherichia coli. 2008, 13.
- Gómez-Heincke, D.; Martínez, I.; Partal, P.; Guerrero, A.; Gallegos, C. Development of Antimicrobial Active Packaging Materials Based on Gluten Proteins. J Sci Food Agric 2016, 96, 3432–3438. [CrossRef]
- Guaña Escobar, F.; Vaca Tenorio, M.; Aguilar, J. Biopelículas y envases activos, nuevas tecnologías en la industria alimentaria. FACSalud UNEMI 2022, 6, 18–32.
- Gheorghita, R.; Filip, R.; Lobiuc, A. Novel Materials with Microencapsulated Essential Oils. Potential Applications for Skin Cellular Regeneration Dressings.; Vienna, Austria, December 15 2023; pp. 483–489.
- Emadian, S.M.; Onay, T.T.; Demirel, B. Biodegradation of Bioplastics in Natural Environments. Waste Management 2017, 59, 526–536. [CrossRef]
- Thakur, R.; Pristijono, P.; Scarlett, C.J.; Bowyer, M.; Singh, S.P.; Vuong, Q.V. Starch-Based Films: Major Factors Affecting Their Properties. International Journal of Biological Macromolecules 2019, 132, 1079–1089. [CrossRef]
- Abdelatti, M.A.I.; Abd El-Aziz, N.K.; El-Naenaeey, E.-S.Y.M.; Ammar, A.M.; Alharbi, N.K.; Alharthi, A.; Zakai, S.A.; Abdelkhalek, A. Antibacterial and Anti-Efflux Activities of Cinnamon Essential Oil against Pan and Extensive Drug-Resistant Pseudomonas Aeruginosa Isolated from Human and Animal Sources. Antibiotics (Basel) 2023, 12, 1514. [CrossRef]
- Bajić, M.; Oberlintner, A.; Kõrge, K.; Likozar, B.; Novak, U. Formulation of Active Food Packaging by Design: Linking Composition of the Film-Forming Solution to Properties of the Chitosan-Based Film by Response Surface Methodology (RSM) Modelling. International Journal of Biological Macromolecules 2020, 160, 971–978. [CrossRef]
- Atarés, L.; Chiralt, A. Essential Oils as Additives in Biodegradable Films and Coatings for Active Food Packaging. Trends in Food Science & Technology 2016, 48, 51–62. [CrossRef]
- Stasiak, J.; Stasiak, D.M.; Libera, J. The Potential of Aquafaba as a Structure-Shaping Additive in Plant-Derived Food Technology. Applied Sciences 2023, 13, 4122. [CrossRef]
- Intikhab, A. Aquafaba: Nutritional Significance for Vegans. A Way towards Environmental Sustainability. L&S 2023, 4, 7. [CrossRef]
- Röhl, V.; van Noordenne-Bos ,Corinne; Wieland ,Hansjörg; Graupner ,Nina; Rottmann-Meyer ,Marie-Luise; and Müssig, J. Effect of Different Natural Fibers on Mechanical and Disintegration Properties of Compostable Biobased Plastics. Journal of Natural Fibers 2023, 20, 2248383. [CrossRef]
- Fayyazbakhsh, A.; Koutný, M.; Kalendová, A.; Šašinková, D.; Julinová, M.; Kadlečková, M. Selected Simple Natural Antimicrobial Terpenoids as Additives to Control Biodegradation of Polyhydroxy Butyrate. International Journal of Molecular Sciences 2022, 23, 14079. [CrossRef]
- Devi, N.; Sarmah, M.; Khatun, B.; Maji, T.K. Encapsulation of Active Ingredients in Polysaccharide–Protein Complex Coacervates. Advances in Colloid and Interface Science 2017, 239, 136–145. [CrossRef]
- Kumari, S.V.G.; Pakshirajan, K.; Pugazhenthi, G. Facile Fabrication and Characterization of Novel Antimicrobial and Antioxidant Poly (3-Hydroxybutyrate)/Essential Oil Composites for Potential Use in Active Food Packaging Applications. Int J Biol Macromol 2023, 252, 126566. [CrossRef]
- Kumari, S.V.G.; Pakshirajan, K.; Pugazhenthi, G. Development and Characterization of Active Poly (3-Hydroxybutyrate) Based Composites with Grapeseed Oil and MgO Nanoparticles for Shelf-Life Extension of White Button Mushrooms (Agaricus Bisporus). International Journal of Biological Macromolecules 2024, 260, 129521. [CrossRef]
- Baffoe, E.; Dauer, E.; Ghahremaninezhad, A. Effect of Proteins on Biocementation in Construction Materials. iScience 2024, 27, 108743. [CrossRef]
- Rolim, H.M.L.; Ramalho, T.C. Chapter 7 - Biopolymer Essential Oil Nanocomposite for Antimicrobial Packaging. In Biopolymer-Based Nano Films; Rai, M., dos Santos, C.A., Eds.; Elsevier, 2021; pp. 115–131 ISBN 978-0-12-823381-8.
- Castro, J.I.; Valencia-Llano, C.H.; Valencia Zapata, M.E.; Restrepo, Y.J.; Mina Hernandez, J.H.; Navia-Porras, D.P.; Valencia, Y.; Valencia, C.; Grande-Tovar, C.D. Chitosan/Polyvinyl Alcohol/Tea Tree Essential Oil Composite Films for Biomedical Applications. Polymers (Basel) 2021, 13, 3753. [CrossRef]
- Hernández-López, M.; Correa-Pacheco, Z.N.; Bautista-Baños, S.; Zavaleta-Avejar, L.; Benítez-Jiménez, J.J.; Sabino-Gutiérrez, M.A.; Ortega-Gudiño, P. Bio-Based Composite Fibers from Pine Essential Oil and PLA/PBAT Polymer Blend. Morphological, Physicochemical, Thermal and Mechanical Characterization. Materials Chemistry and Physics 2019, 234, 345–353. [CrossRef]
- Callisaya, A.C.; Mendoza, G.J.C. Extracción de almidón de papa (Solanum tuberosum), yuca (Manihot esculenta), camote (Ipomoea batatas). Revista Estudiantil AGRO-VET, Universidad Mayor de San Andrés 2022, 6, 22.
- Bayona Buitrago, C.A.; Cepeda, M.F.; León Castrillo, L.C. Aprovechamiento de los subproductos agroindustriales de la cadena productiva de la yuca (manihot esculenta): una revisión. Revista @Limentech: Ciencia y Tecnología Alimentaria 2022, 20, 92–110.
- Oliveira, G.L. de; Verdenelli, R.A.; Dominchin, M.F.; Zygadlo, J.A.; Meriles, J.M. Impacto de los aceites escenciales y monoterpenos sobre la nitrificación y las comunidades microbianas edáficas. Ciencia del Suelo 2018, 36.
- Mustafa, R.; He, Y.; Shim, Y.Y.; Reaney, M.J.T. Aquafaba, Wastewater from Chickpea Canning, Functions as an Egg Replacer in Sponge Cake. International Journal of Food Science & Technology 2018, 53, 2247–2255. [CrossRef]
- Yazici, G.N.; Taspinar, T.; Ozer, M.S. Aquafaba: A Multifunctional Ingredient in Food Production. Biology and Life Sciences Forum 2022, 18, 24. [CrossRef]
- Fogašová, M.; Figalla, S.; Danišová, L.; Medlenová, E.; Hlaváčiková, S.; Vanovčanová, Z.; Omaníková, L.; Baco, A.; Horváth, V.; Mikolajová, M.; et al. PLA/PHB-Based Materials Fully Biodegradable under Both Industrial and Home-Composting Conditions. Polymers 2022, 14, 4113. [CrossRef]
- Cano, C.; Bonilla, P.; Roque, M.; Ruiz, J. Actividad Antimicótica in Vitro y Metabolitos Del Aceite Esencial de Las Hojas de Minthostachys Mollis (Muña). Revista Peruana de Medicina Experimental y Salud Publica 2008, 25, 298–301.
- Mares Jiménez, A.C.; Prado Rebolledo, O.F.; Hernandez Rivera, J.A.; Mendoza Muñoz, N.; García Casillas, A. Aceites esenciales y sus constituyentes para hacer frente a las bacterias patógenas. Abanico veterinario 2024, 15, 14.
- Sanla-Ead, N.; Jangchud, A.; Chonhenchob, V.; Suppakul, P. Antimicrobial Activity of Cinnamaldehyde and Eugenol and Their Activity after Incorporation into Cellulose-Based Packaging Films. Packaging Technology and Science 2012, 25, 7–17. [CrossRef]
- Maurya, A.; Prasad, J.; Das, S.; Dwivedy, A.K. Essential Oils and Their Application in Food Safety. Front. Sustain. Food Syst. 2021, 5. [CrossRef]
- Martínez, A.; Manrique-Moreno, M.; Klaiss-Luna, M.C.; Stashenko, E.; Zafra, G.; Ortiz, C. Effect of Essential Oils on Growth Inhibition, Biofilm Formation and Membrane Integrity of Escherichia Coli and Staphylococcus Aureus. Antibiotics 2021, 10, 1474. [CrossRef]
- Gomes, D.S.; da Costa, A.; Pereira, A.M.; Casal, M.; Machado, R. Biocomposites of Silk-Elastin and Essential Oil from Mentha Piperita Display Antibacterial Activity. ACS Omega 2022, 7, 6568–6578. [CrossRef]

| Formulation | Water (mL) | Aq (mL) | CEO (% p/p) | Starch (g) | Guar gum (g) | Glicerol (mL) | Mg Estearate (g) | Grape stalk (g) |
|---|---|---|---|---|---|---|---|---|
| Aq-CEO-7.5% | 0 | 100 | 7.5 | 35 | 1 | 10 | 0.4 | 20 |
| Aq-CEO-0% | 0 | 100 | 0 | 35 | 1 | 10 | 0.4 | 20 |
| W-CEO-7.5% | 100 | 0 | 7.5 | 35 | 1 | 10 | 0.4 | 20 |
| W-CEO-0% | 100 | 0 | 0 | 35 | 1 | 10 | 0.4 | 20 |
| Grape Stalk | Aquafaba | Aq-CEO | W-CEO | |
|---|---|---|---|---|
| Protein (%) | 3.82±0.04 | 20.99±0.11 | 1.03±0.01a | 1.03±0.02a |
| Lipids (%) | 0.95±0.01 | 8.57±0.05 | 0.74±0.06a | 0.77±0.01a |
| Ash (%) | 3.26±0.03 | 1.14±0.03 | 0.69±0.01a | 0.65±0.04a |
| Fibre (%) | 54.54±0.03 | 1.77±0.06 | 4.24±0.11a | 3.58±0.09b |
| NFE(%) | 26.82±0.02 | 64.61±0.20 | 46.61±0.05a | 47.1±0.09b |
| Holocelullose (%) | 43±0.12 | |||
| Alpha Cellulose (%) | 18±0.03 | |||
| Lignin (%) | 19±0.09 | |||
| Hemicellulose (%) | 25±0.14 |
| Formulation | WAC-75%R.H (%) |
WAC-98%R.H (%) |
Maximum Resistance (N) |
|---|---|---|---|
| W-CEO-7.5% | 5.0±0.625a | 5.84±0.358a | 22.1±1.925a |
| W-CEO-0% | 11.0±0.957b | 12.5±0.625b | 10.4±0.182b |
| Aq-CEO-7.5% | 5.4±1.30a | 6.04±1.30a | 44.7±2.493c |
| Aq-CEO-0% | 10.8±1.30b | 11.7±1.58b | 33.7±3.254d |
Disclaimer/Publisher’s Note: The statements, opinions and data contained in all publications are solely those of the individual author(s) and contributor(s) and not of MDPI and/or the editor(s). MDPI and/or the editor(s) disclaim responsibility for any injury to people or property resulting from any ideas, methods, instructions or products referred to in the content. |
© 2025 by the authors. Licensee MDPI, Basel, Switzerland. This article is an open access article distributed under the terms and conditions of the Creative Commons Attribution (CC BY) license (http://creativecommons.org/licenses/by/4.0/).
